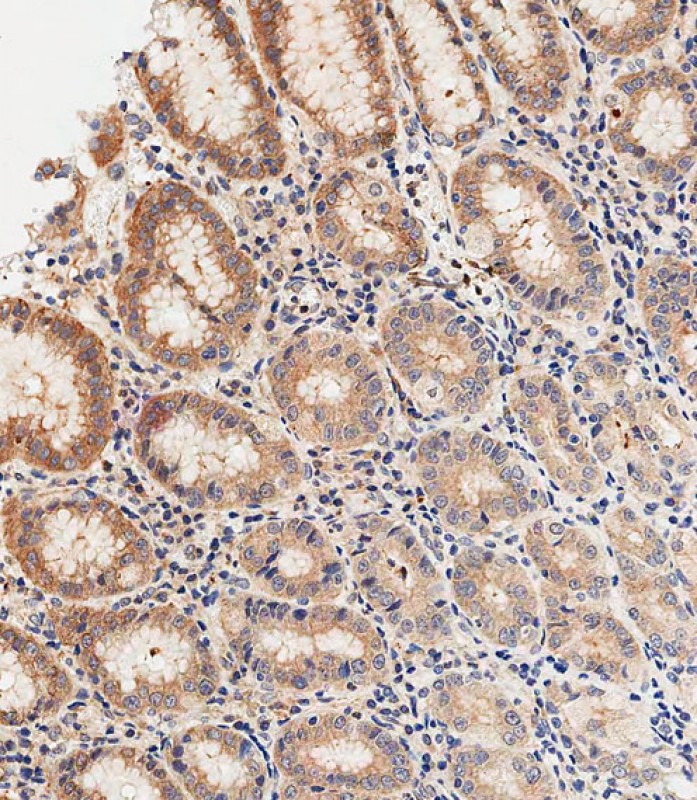

-
分类: 科研抗体货号: P34596别名: Neutrophil defensin 1, Defensin, alpha 1, HNP-1, HP-1, HP1, HP 1-56, Neutrophil defensin 2, HNP-2, HP-2, HP2, DEFA1, DEF1, DEFA2, MRS应用: WB反应种属: Human
-
分类: 科研抗体货号: P34630别名: Histone-lysine N-methyltransferase 2D, Lysine N-methyltransferase 2D, ALL1-related protein, Myeloid/lymphoid or mixed-lineage leukemia protein 2, KMT2D, ALR, MLL2, MLL4应用: RWB反应种属: Human, Mouse
-
分类: 科研抗体货号: P34612别名: F-box/LRR-repeat protein 2, F-box and leucine-rich repeat protein 2 {ECO:0000312|HGNC:HGNC:13598}, F-box protein FBL2/FBL3 {ECO:0000303|PubMed:10945468, ECO:0000312|EMBL:AAF045101}, FBXL2 (<a href="http://www.genenames.org/cgi-bin/gene_symbol_report?hgnc_应用: WB,IHC,FCM反应种属: Human, Mouse, Rat
-
分类: 科研抗体货号: P34594别名: Alpha-1D adrenergic receptor, Alpha-1A adrenergic receptor, Alpha-1D adrenoreceptor, Alpha-1D adrenoceptor, Alpha-adrenergic receptor 1a, ADRA1D, ADRA1A应用: WB,FCM反应种属: Human, Mouse, Rat
-
分类: 科研抗体货号: P34610别名: Heat shock 70 kDa protein 1A/1B, Heat shock 70 kDa protein 1/2, HSP70-1/HSP70-2, HSP70.1/HSP70.2, HSPA1A, HSPA1, HSX70应用: WB反应种属: Human, Mouse, Rat
-
分类: 科研抗体货号: P34629别名: M-phase inducer phosphatase 1, 3.1.3.48, Dual specificity phosphatase Cdc25A, CDC25A应用: WB,IHC反应种属: Human, Mouse, Rat
-
分类: 科研抗体货号: P34593别名: Protein spinster homolog 2, SPNS2应用: WB,FCM反应种属: Human, Mouse
-
分类: 科研抗体货号: P34609别名: Deoxyribonuclease-1, Deoxyribonuclease I, DNase I, Dornase alfa, DNASE1, DNL1, DRNI应用: WB,IHC反应种属: Human, Mouse
-
分类: 科研抗体货号: P34627别名: 60S ribosomal protein L10, Laminin receptor homolog, Protein QM, Tumor suppressor QM, RPL10, DXS648E, QM应用: WB反应种属: Human, Mouse, Rat

鄂公网安备42018502007531号
鄂公网安备42018502007531号

